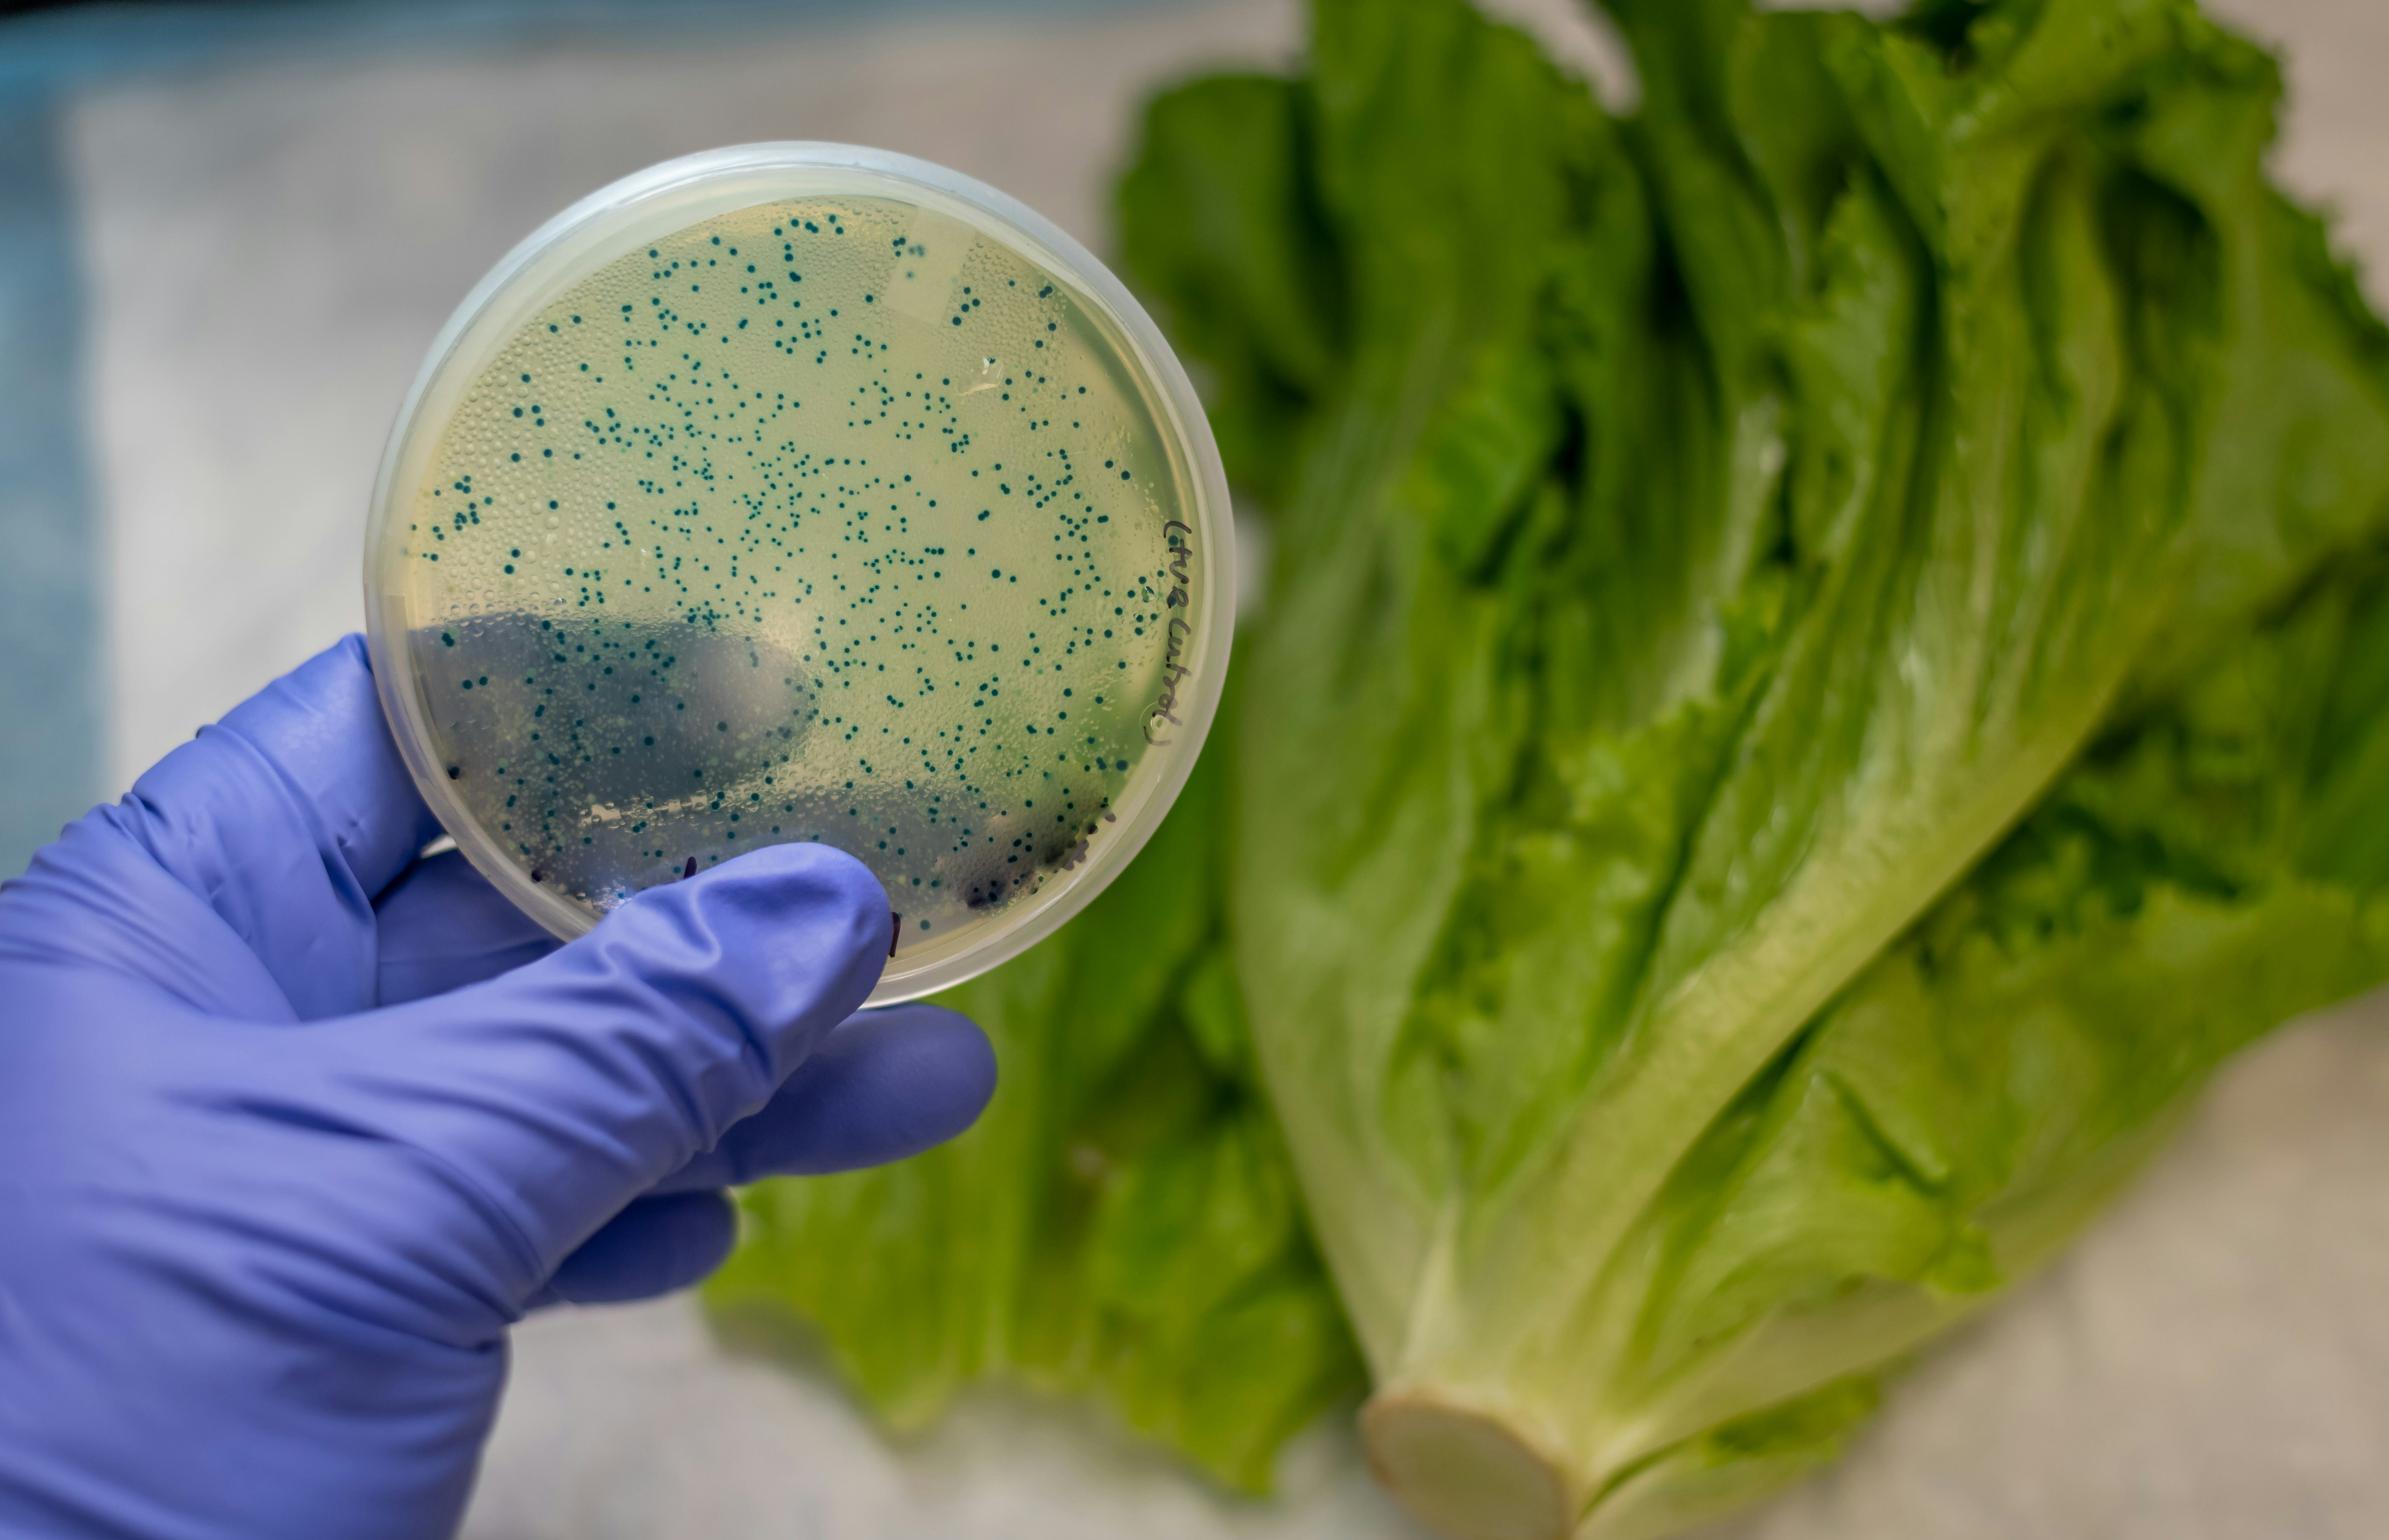

At the start of the summer, I had a gnarly bout of food poisoning. The morning after eating chicken nachos at a bar, I woke up with crippling cramps, a horrifying harbinger of food-poisoning. I spent the next 12 hours ejecting everything in my stomach in agony, unable to consume even the smallest bit of water without triggering more spasms.
When the vomiting and diarrhea (sorry for the imagery) was finally over, I thought I was out of the woods with nothing but mild nacho-induced PTSD. But during the next few months, I experienced sporadic, painful stomach cramps. There was a resurgence of IBS symptoms that had remained under control since I was diagnosed eight years ago and put on the low-FODMAP diet — a regimen that eliminates all notorious food offenders that provoke the gut — and given a prescription med to reduce my GI tract’s reactivity.
Weeks after my nightmarish encounter with those nachos, I did a little research and discovered that even a single bout of foodborne illness could yield long-term effects, according to the CDC, ranging from reactive arthritis to Irritable Bowel Syndrome (IBS), and chronic kidney disease.
Hemolytic-uremic syndrome (HUS), an illness that affects blood and blood vessels, can pop up after an E.coli infection, says Amesh Adalja, an infectious disease specialist and senior scholar at the Johns Hopkins Center for Health Security. People who experience HUS may also be at risk for other kidney-related problems down the line; salmonella can lead to bloodstream infections that can be associated with aneurysms in blood vessels, he adds.
If all this crazy stuff can happen after something as common as food poisoning — and does happen to roughly 200,000 people in the U.S. every year — why wasn't I aware of it?

I mean, we’ve literally all had a bad-food-induced stomach explosion at some point. Each year, 1 in 6 Americans encounters the effects of foodborne bacteria. There are hundreds of pathogens (cue horror movie music) that can shimmy their way onto your plate, causing symptoms nearly immediately afterward.
It can also be hard to tell whether you’re dealing with the stomach flu or a foodborne illness in many cases, says William Schaffner, physician and professor of medicine in the Division of Infectious Diseases at Vanderbilt University. “These intestinal infections are caused by viruses and bacteria. Sometimes, the transmission is person to person. Other times, it’s food to person.” Food poisoning occurs via the latter route.
Bacteria Clostridium perfringens and Campylobacter mostly bring on diarrhea within hours to a few days, whereas with norovirus, you may have a rapid onset of both. “Staph affects the upper part of the GI tract, so you can become sick very quickly,” Schaffner says, noting it can be just an hour or two in some cases. “You may have a little diarrhea, but the predominant symptom with staph is vomiting and nausea.” E.coli and salmonella, on the other hand, will take 24 to 48 hours to hit you like a ton of bricks, and will often involve diarrhea and cramping, Schaffner says.
You can’t necessarily tell which food has been contaminated with a harmful bacteria, so the only way to avoid getting sick is dodging these hell-raisers by using preventative measures.
It’s fairly unlikely that your food poisoning experience will have long-term effects, but it’s also important to be mindful that they’re a possibility, especially considering the strength of some of those gut-churning bacteria. One of the most common after-effects, as in my life, is IBS; Research suggests some 10 percent experience post-infection IBS. Chronic sensitivity — which is something like having IBS — is a possibility too, says Schaffner.
Numerous foodborne bacteria have also been linked to Reiter Syndrome, otherwise known as reactive arthritis. “These bacteria set off an unusual immune response,” says Schaffner. “This can trigger reactive arthritis and periodic inflammation of the joints. This might happen several weeks, or maybe a month,after the original symptoms have cleared up.”
Anyone can end up with long-term effects of foodborne pathogens, but those with compromised immune systems, children, and older adults are most at risk. That’s why those individuals, specifically, should seek early medical care in the event they’re sick, losing body liquids fast, and don’t see any signs of a slowdown, according to Jennifer Behzadi, a gastroenterologist at the Ohio State University Wexner Medical Center. “While some people will get better with conservative treatment at home, you’ll want to consider seeking medical care if you get dehydrated, are unable to maintain oral intake like liquids for 24 hours, have a high fever, see blood, or have prolonged symptoms,”says Behzadi.
And if you do develop additional weird symptoms and suspect food poisoning — your diarrhea keeps recurring, you’re experiencing swollen knees or fingers — get to a doctor and explain exactly what went down. The earlier you can get necessary treatment, the better off you are in the long run. “Oftentimes, a doctor can have a tough time figuring out why a person is experiencing symptoms,” says Schaffner, noting that providing a thorough medical history can help your physician nail the diagnosis and get you treatment.
You can’t necessarily tell which food has been contaminated with a harmful bacteria, so the only way to avoid getting sick is dodging these hell-raisers by using preventative measures. Kitchen hygiene is crucial. “We always say to wash your hands thoroughly, as well as cutting boards that you’re using,” he says. “If you prepare chicken on a cutting board, and then cook it, the heat kills off all the bacteria. If you place it back on the cutting board before serving, you just re-contaminated it.”
The more thoroughly cooked your food is, the less likely you are going to contract a bug, says Adalja. Make sure the knife you cut your raw meat with is not also the knife you’re using to cut raw veggies (which should be washed thoroughly) immediately after. While it can feel natural and necessary, don’t wash your meat before you cook it; this won’t do anything to reduce the risk of food poisoning, and actually increases the risk of spreading bacteria for an outbreak. And while this feels like a given, food handlers should be free from illness and practice good hygiene, so avoid any glove-less or sneezing restaurant food-preppers.
If you’re placing food outside, make sure every single item “is either cold or hot” when it hits a plate, says Schaffner; bacteria like staph spreads easily among food that’s just been chilling on a table for a few hours. As for leftovers, get that stuff in your fridge within two hours of cooking. Lastly, pay attention to reports of foodborne illness and recalls on the TV and internet. “If you have a bag of lettuce or another food that’s being recalled, it’s not worth the $3,” Schaffner says, of rolling the dice. I know, lettuce can be expensive and wasting food sucks, but I only get one body, so “when in doubt, throw it out” is the motto I now live by.